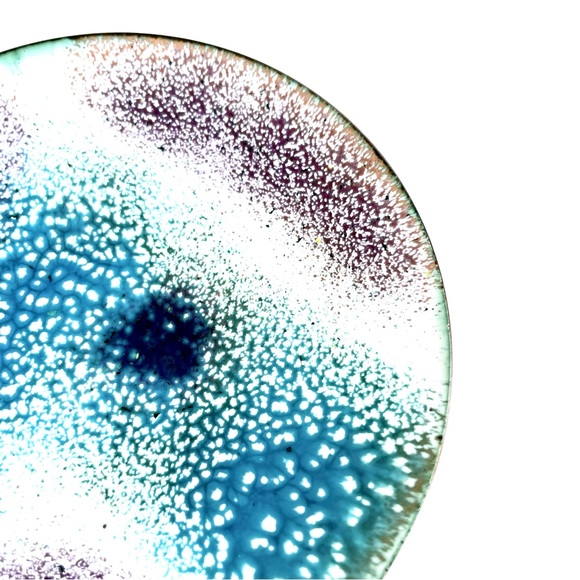
Vintage Enamelled Copper Trinket Dish - Picture 10 of 15

Vintage Enamelled Copper Trinket Dish
$29
Size
Not for sale
Like and save for later
Vintage Enamelled Copper Trinket Dish.
Beautiful white, purple, teal, green, and dark indigo colours. Great for storing jewelry. Makes a perfect gift!
There are more enamelled trinket dishes listed in my closet. BUNDLE them together to make a set and SAVE!
Perfect vintage condition. No flaws. Please see the photos for details.
This listing is for one dish only. Jewelry not included.
*OFFERS WELCOME!*
Shipping/Discount



nnuthals
and
2 others
like this
Trending Now
Find Similar Listings
Account is under Review
Comment posting is temporarily restricted. Our team will reach out to you shortly. To understand why, select
Learn More.